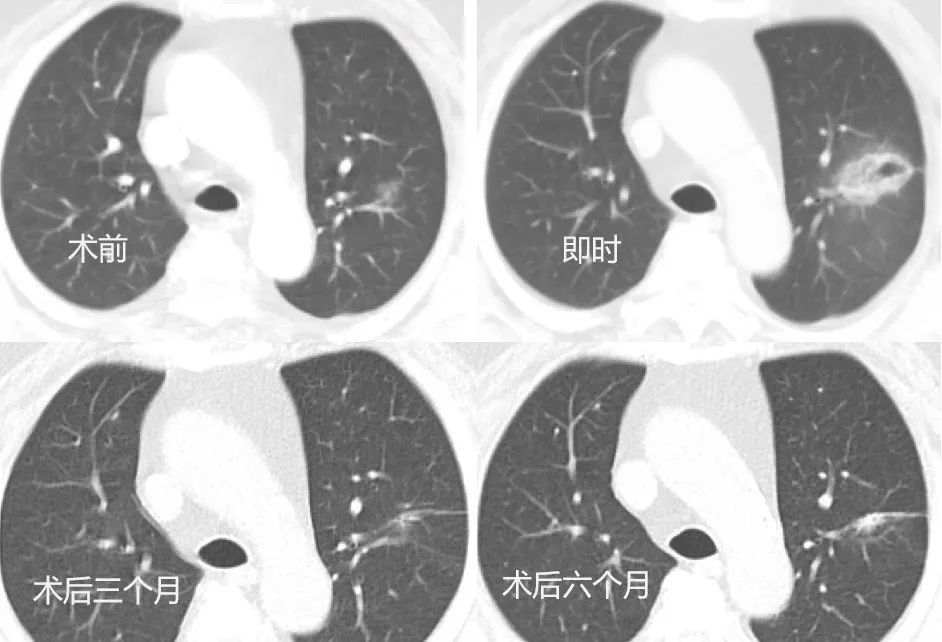
1745915672555057.jpg

天津医科大学总医院肺部肿瘤外科
于2023年底
在国内率先开展冷热复合式消融技术
为肺部肿瘤的治疗
带来全新的思路和方法
外科技术引领下的
多学科个体化消融诊疗新范式

冷热复合式消融技术的独特之处首先体现在它以外科技术为核心,巧妙地融合了冷热复合式消融理念。在治疗过程中,科室依托先进的多学科协作诊疗(MDT)模式,组织多领域专家对患者的肿瘤特征、全身状况以及治疗耐受性进行全面而细致的综合评估。这种精准的评估体系能够根据患者的具体情况,在微创腔镜手术、介入消融等多种治疗策略中,为患者量身定制个体化的治疗方案。

高风险患者的肺部肿瘤治疗新希望与技术进阶之路

“杂交手术” 与全程化管理书写肺部肿瘤治疗新答卷
针对肺部多发结节治疗难题,天津医科大学总医院肺部肿瘤外科创新推出 “胸腔镜微创 + 冷热复合式消融” 的 “杂交手术” 模式。该技术避免传统手术对肺功能的损伤,让无法单一术式根治的患者获得更彻底治疗,目前占科室消融治疗总量 10%,实现肺功能保护与肿瘤控制率双提升。在此基础上,科室将冷热复合式消融技术应用于局部晚期肺部肿瘤的姑息治疗,与靶向、免疫、放疗等手段结合,形成 “局部 - 全身” 全程化管理模式,有效缓解患者症状、控制病情、延长生存期。
经过一年实践,冷热复合式消融技术已成为科室肺部肿瘤治疗的核心技术,塑造了学科特色优势与品牌竞争力。
创新消融技术点亮肺部肿瘤患者康复之路

【专家介绍】

【专业擅长】:肺移植,肺部及纵膈肿瘤的个体化治疗,在肺癌的诊断、手术治疗及综合治疗方面积累了丰富的临床经验,特别是一些高难度的手术,手术技巧高超,经验丰富。

刘京豪
【专业擅长】:外科为主的肺部肿瘤消融手术以及相关杂交手术、肺及纵膈肿瘤的微创外科治疗。
来源:天津医科大学总医院